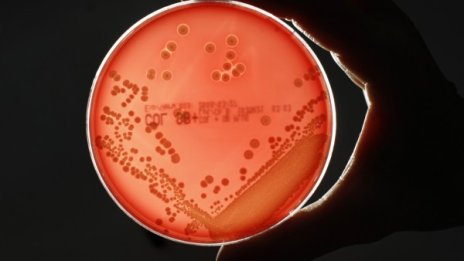

Новини
-
Jägermeister ORANGE – новият лек и цитрусов вкус вече в България
-
Шишков: От години е имало признаци, че свлачището ще се активира
-
ДБ: Пеевски включва прокуратурата си и смачка сигнала за уреждане на обществени поръчки
-
Как да изберем мед и защо произходът има значение?
-
Добри условия за туризъм в планините, но се очаква влошаване
-
Ценови натиск, риск от фалити и арбитраж: КЗК предлага спешни мерки за горивата
-
Русия достави ядрени боеприпаси в Беларус в рамките на военни учения
-
DARA "уволни" шефа на телевизията в Молдова
-
Да "намажеш филията" с DARA
-
Кабинетът приема изменения в Наредбата за пенсиите и осигурителния стаж
-
Хореографът на Бангаранга: Дара имаше важна роля в развитието на танца
-
Как Русия се опита да си присвои победата на България на Евровизия?
-
Шон Пол, който взриви София, а тя... вече му отива (СНИМКИ)
-
Отиде си легенда на художествената ни гимнастика
-
Дара: Трябваше ми много време, за да простя на народа си за хейта
-
Как Русия се опита да си присвои победата на България на Евровизия?
-
Украйна извършва най-голямата въздушна атака срещу Москва от Втората световна война насам
-
Да "намажеш филията" с DARA
-
Радев разговарял с Тръмп и Хегсет, военните самолети на САЩ може и да останат на летище София
-
Румен Радев: Не искаме таван на надценките, а прозрачност по цялата верига ВИДЕО
-
Хиляди посрещнаха Дара, пеят Bangaranga в сърцето на столицата СНИМКИ

Експерт: Високите оценки на технологичните компании в САЩ няма да се запазят
Експерт: Високите оценки на технологичните компании в САЩ няма да се запазят  „Компас Инвест" с нови капиталово защитени продукти с Goldman Sachs с 12,8% годишен купон в USD и 7,8% в EUR
„Компас Инвест" с нови капиталово защитени продукти с Goldman Sachs с 12,8% годишен купон в USD и 7,8% в EUR  Документите за IPO-то на SpaceX разкриха загуба за 2 млрд. долара и здравата хватка на Мъск
Документите за IPO-то на SpaceX разкриха загуба за 2 млрд. долара и здравата хватка на Мъск  Защо инвестицията в качествени инструменти спестява разходи в дългосрочен план
Защо инвестицията в качествени инструменти спестява разходи в дългосрочен план  Петролът леко поскъпва въпреки оптимизма около евентуално споразумение между САЩ и Иран*
Петролът леко поскъпва въпреки оптимизма около евентуално споразумение между САЩ и Иран*  Всички големи рафинерии в Централна Русия са ударени от украински дронове
Всички големи рафинерии в Централна Русия са ударени от украински дронове 
 Промените в НС: Ще имаме ли законодателен процес на тъмно
Промените в НС: Ще имаме ли законодателен процес на тъмно  Шишков: Свлачището на пътя Смолян - Пампорово остава активно
Шишков: Свлачището на пътя Смолян - Пампорово остава активно  Цените на горивата: Ще плащаме повече поне до края на годината
Цените на горивата: Ще плащаме повече поне до края на годината  Близо 500 хил. автомобила ще напуснат София около 24 май
Близо 500 хил. автомобила ще напуснат София около 24 май  Повишена опасност от мълнии до неделя: Експерт съветва как да се предпазим
Повишена опасност от мълнии до неделя: Експерт съветва как да се предпазим  Петролът поскъпва на фона на преговорите между САЩ и Иран
Петролът поскъпва на фона на преговорите между САЩ и Иран 
 Сашо Димитров надъха националите по минифутбол за Европейското
Сашо Димитров надъха националите по минифутбол за Европейското  БФС със специално съобщение и пожелание към ЦСКА
БФС със специално съобщение и пожелание към ЦСКА  Кошмара разкри защо е дошъл в ЦСКА
Кошмара разкри защо е дошъл в ЦСКА  Кръвно свързан с ЦСКА ликува и трогна всички: Тате, за дядо е това!
Кръвно свързан с ЦСКА ликува и трогна всички: Тате, за дядо е това!  ЦСКА е №1! Вижте точно колко трофея имат във витрината си армейците
ЦСКА е №1! Вижте точно колко трофея имат във витрината си армейците  Ужас! Пребиха фен на ЦСКА след финала за Купата
Ужас! Пребиха фен на ЦСКА след финала за Купата 
 Силни поверия за Спасовден
Силни поверия за Спасовден  Остават броени дни до концерта на Iron Maiden на 26 май на стадион „Васил Левски“
Остават броени дни до концерта на Iron Maiden на 26 май на стадион „Васил Левски“  Италианска салата с картофи и риба тон
Италианска салата с картофи и риба тон  Задължителни ястия за 21 май – Константин и Елена
Задължителни ястия за 21 май – Константин и Елена  „Ехо в смъртта“ от Нора Робъртс
„Ехо в смъртта“ от Нора Робъртс  5 топ прически с минимална поддръжка
5 топ прически с минимална поддръжка 
 продава, Парцел, 1118 m2 Пловдив област, с.Костиево, 115000 EUR
продава, Парцел, 1118 m2 Пловдив област, с.Костиево, 115000 EUR  продава, Едностаен апартамент, 50 m2 София, Банишора, 100000 EUR
продава, Едностаен апартамент, 50 m2 София, Банишора, 100000 EUR  продава, Двустаен апартамент, 70 m2 Перник област, с.Студена, 109000 EUR
продава, Двустаен апартамент, 70 m2 Перник област, с.Студена, 109000 EUR  продава, Тристаен апартамент, 110 m2 София, Манастирски Ливади, 391680 EUR
продава, Тристаен апартамент, 110 m2 София, Манастирски Ливади, 391680 EUR  продава, Земеделски имот, 17550 m2 София област, гр. Ихтиман, 179500 EUR
продава, Земеделски имот, 17550 m2 София област, гр. Ихтиман, 179500 EUR  продава, Двустаен апартамент, 81 m2 София, Манастирски Ливади, 184200 EUR
продава, Двустаен апартамент, 81 m2 София, Манастирски Ливади, 184200 EUR 
 Търсят спасители за 8 от 27-те неохраняеми плажове във Варненско
Търсят спасители за 8 от 27-те неохраняеми плажове във Варненско  Министърът на туризма идва във Варна за подготовката на летния сезон
Министърът на туризма идва във Варна за подготовката на летния сезон  ИАРА погна любителите рибари във Варна
ИАРА погна любителите рибари във Варна  Акция: Полицията погна дилърите на дрога във Варна (СНИМКИ)
Акция: Полицията погна дилърите на дрога във Варна (СНИМКИ)  Полицаи преследваха мъж без книжка край Варна
Полицаи преследваха мъж без книжка край Варна  Хороскоп за 22 май 2026
Хороскоп за 22 май 2026 
 Psyche получи гравитационен тласък от Марс: Увеличи скоростта си с 1600 км/ч (снимки)
Psyche получи гравитационен тласък от Марс: Увеличи скоростта си с 1600 км/ч (снимки)  Луната, звездният куп „Ясли“ и трио планети красят небето на 21 май
Луната, звездният куп „Ясли“ и трио планети красят небето на 21 май  Гледайте на живо: SpaceX изстрелва новата си мегаракета Starship V3 на 21 май
Гледайте на живо: SpaceX изстрелва новата си мегаракета Starship V3 на 21 май  Откриха нов вид „усмихнат“ паяк в Хималаите
Откриха нов вид „усмихнат“ паяк в Хималаите  Разгадана е мистерията около произхода на вулкана Етна
Разгадана е мистерията около произхода на вулкана Етна  Гърбат кит постави абсолютен рекорд с епично пътешествие до Австралия
Гърбат кит постави абсолютен рекорд с епично пътешествие до Австралия